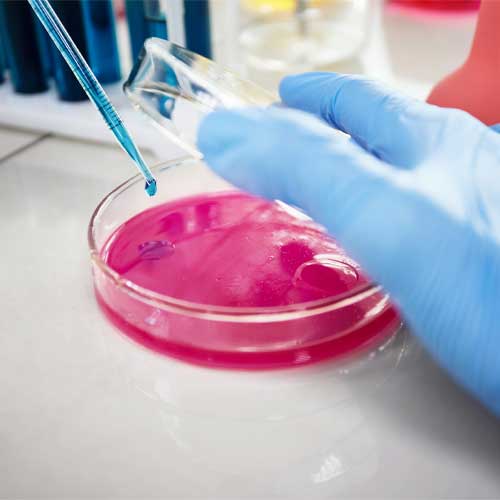

Nosotros


Somos un servicio especializado en el análisis macro y microscópico de especímenes anatomopatológicos, dando un soporte científico a las diferentes especialidades médicas, basados en las técnicas microscópicas disponibles. Para ello contamos con un equipo humano y tecnológico entrenado y diseñado para tal fin, basados en principios éticos y comprometidos con la calidad. Logrando resultados satisfactorios para los clientes, colaboradores y accionistas.

En el año 2025 CORPOPAT S.A.S será un laboratorio reconocido a nivel nacional por su constante actualización para alcanzar los más altos estándares de calidad y consolidarnos como centro de referencia nacional.

Servicios
Efectivo, eficaz y oportuno, con calidad humana y científica.
Calidad
El estudio y reporte patológico de las muestras analizadas se realizan bajo los más altos estándares de procesamiento e interpretación.
Innovación
Tiene importante relevancia como herramienta de gestión, a través de los resultados generamos confianza y calidad en beneficio del usuario.
Oportunidad
El análisis histológico e interpretación de estudios adicionales se realizan en el menor tiempo posible.
Compromiso
En el año 2025 CORPOPAT S.A.S será un laboratorio reconocido a nivel nacional por su constante actualización para alcanzar los más altos estándares de calidad y consolidarnos como centro de referencia nacional.
Confidencialidad
Es uno de nuestros principales valores ya que el análisis histológico e interpretación de estudios adicionales se realizan en el menor tiempo posible, para otorgar un diagnostico adecuado y a tiempo.